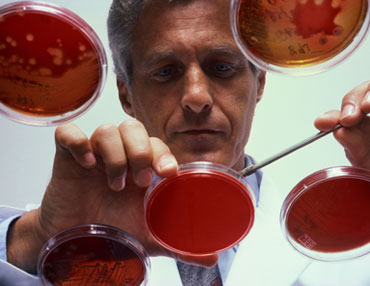

Research
Research
Our foundation has a proud history of supporting research into genetic eye conditions, including contributing to genetic research with the Prince of Wales Hospital. We thank you for your contributions to this research, it is very much appreciated and used immediately.

LOOK FOR LIFE FOUNDATION – MATTHEW IP

Dr Matthew Hochuen Ip is a current Senior Resident Medical Officer at the Prince of Wales Hospital Eye Clinic, specializing under Ophthalmology. Matthew graduated from the University of New South Wales (BMed, MD; 2016) with Distinction. He has been acquainted with Professor Minas Coroneo since 2013 and till present has continued his passion for ophthalmology and vision sciences under the tutelage of Professor Coroneo and the Prince of Wales Hospital Eye Clinic.
Matthew’s research interests focus on the pathology and treatment of ultra-violet associated ocular surface disease. Additional interests include identifying rates of relapse and outcomes post-pterygium surgery and finding associations with different surgical techniques employed. He is concurrently completing a Master of Surgery, due to be finished by 2019’s end, titled: “The burden of ultraviolet light associated ocular surface pathology. Setting the scene for the novel methods in their assessment and management.” For his efforts, Matthew has been awarded a prestigious Postgraduate Research Scholarship (2019) to further assist his completion of his Master of Surgery. More recently, Matthew had been awarded a Research Travel Grant from the Prince of Wales Hospital Clinical School (2019), to present at The Association for Research in Vision and Ophthalmology Annual Meeting (2019) in Vancouver, Canada. This conference incorporates over 11,000 vision scientists and expert clinicians and is the largest conference worldwide for the theme of Ophthalmology/Vision Sciences. His presentation, titled Ocular surface neoplasia, a now medically treatable disease spectrum?, details remarkable post-treatment outcomes of patients with corneal-conjunctival intraepithelial neoplasia (OSSN) treated with topical combination eye drops, with <3% recurrence rates with patients reviewed regularly over a ~10-year period. For those resistant to treatment, topical antiviral therapy was employed with promising results. His presentation was nominated a “Hot Topic” delegation (awarded <2% of all accepted abstracts) by the Selection Committee for being an emerging trend or most innovative topic.
Matthew has published several articles (see list below) in internationally peer reviewed journals. These include reputable journals on ophthalmology and vision sciences such as Ophthalmology, Cornea and JAMA Ophthalmology. One paper of interest outlines the identification of Fuchs’ Flecks at the advancing head of Pterygium/Pingueculum which may signify precursor lesions for both these pathologies. Furthermore, he is currently embarking on manuscripts focused on the post-operative outcomes of pterygium, whether there is a correlation between handedness and pterygium distribution on the eye surface and finally whether conjunctival melanomas can be addressed with topical chemotherapeutic agents. Matthew has reported on the successful use of topical chemotherapy for treating pre-cursor melanoma lesions upon the ocular surface with long-term tumour-free follow-up. He has been awarded twice (2015 and 2018) the COSSOM Association Prize for Best Research Presentation for the high quality of his research material. Matthew has co-authored with Professor Coroneo a book chapter on The Management of Recurrent Pterygium (Chapter 145, Cornea, 5th Edition).
Apart from Matthew’s academic achievements, he is also a clinician and teacher for junior medical staff and medical students. During his junior medical officer years at Liverpool Hospital, Matthew was awarded a Peer Education Award on behalf of the South Western Sydney Clinical School and was recognized with the prestigious Clinical Dean’s List Award for the excellence and quality of his teaching. He continues to embark on teaching endeavours on behalf of the Prince of Wales Hospital Clinical School.
Publications
Ip MH, Tat L, Coroneo MT. Primary acquired melanosis treated with combination interferon/retinoic acid Ophthalmology 2018; S0161-6420(18)30773-5. DOI: 10.1016/j.ophtha.2018.07.002
Ip MH, George R, Naing Z, Perlman EM, Rawlinson W, Coroneo MT. Topical cidofovir for treatment-refractory ocular surface squamous neoplasia Ophthalmology 2017; S0161-6420(17)33439-5. DOI: 10.1016/j.ophtha.2017.11.021.
Ip MH, Coroneo MT. The management of previously refractory ocular surface squamous neoplasia with topical cidofovir. JAMA Ophthalmology 2017; 135: 500-502; DOI:10.1001/jamaophthalmol.2017.0365
Ip MH, Chui JJ, Tat L, Coroneo MT. The significance of Fuchs’ flecks in patients with pterygium/pinguecula: earliest indicator of ultraviolet light damage? Cornea 2015; 34: 1560-1563; DOI: 10.1097/ICO.0000000000000621
Mendoza PR, Craven CM, Ip MH, Wilson MW, Coroneo MT, Grossniklaus HE. Conjunctival squamous cell carcinoma with corneal stromal invasion in presumed pterygia: a case series Ocular Oncology and Pathology 2018; 4:240-249. DOI: 10.1159/000485425
Book Chapters
Coroneo MT, Tan JCK, Ip MH. Chapter 145: Management of Recurrent Pterygium; Cornea, 5th Edition – Volume II: Surgery of the Cornea and Conjunctiva by M Mannis & E Holland, 2019. Elsevier – London [in-press]
Presentations (Paper/Poster/Meetings)
Ip MH, Coroneo MT. Ocular surface squamous neoplasia, a now medically treatable disease spectrum? Investigative Ophthalmology and Visual Science
Poster Presentation at The Association for Research in Vision and Ophthalmology Annual Meeting 2019, 30th of April, 2019, Vancouver, British Columbia, Canada; 3575-A0616, Session 357
Ip MH, Coroneo MT. Ocular Surface Squamous Neoplasia, a disease spectrum best treated medically?
Paper Presentation at Cornea and Eye Banking Forum (The Cornea Society) 2018, 26th of October 2018, Chicago, IL, United States of America
Ip MH, George R, Rawlinson W, Coroneo MT. Successful treatment of recurrent ocular surface squamous neoplasia (OSSN) with topical cidofovir. Investigative Ophthalmology and Visual Science
Paper Presentation at The Association for Research in Vision and Ophthalmology Annual Meeting 2016, 01-05th May 2016, Seattle, WA, United States of America; #1367, Session 206
Ip MH, Chui JJ, Tat L, Coroneo MT. The clinical significance of Fuchs’ flecks in pterygia and pinguecula: are Fuchs’ flecks an early indicator of ultraviolet light damage. Investigative Ophthalmology and Visual Science June 2015; Vol. 56, 1624.
Poster Presentation at The Association for Research in Vision and Ophthalmology Annual Meeting 2015, 03-07th May 2015, Denver, CO, United States of America; #1624-D0132
LOOK FOR LIFE FOUNDATION – JEREMY TAN

Dr Jeremy Tan is an ophthalmology registrar at the Prince of Wales Hospital, Sydney. He graduated from the University of New South Wales (UNSW) with an MBBS in 2013. He worked at the St George, Sutherland and Sydney Eye Hospitals before commencing ophthalmology training at the Prince of Wales Hospital. As part of his undergraduate medical degree he spent a research year investigating the ocular complications of autoimmune blistering skin diseases and inherited epidermolysis bullosa. Dr Tan maintains a strong interest in research and teaching. He has published in international peer-reviewed journals and is involved in teaching medical students as a conjoint associate lecturer at UNSW. In his free time he enjoys playing soccer and serving in his local church.
Publications:
- 1. Tan, J.C.K., Ferdi, A., Gillies, M., Watson, S. Clinical registries in ophthalmology. Ophthalmology. In press, 2019.
- 2. Tan, J.C.K., Vollmer-Conna, U., Tat, L., Coroneo, M.T. Dry-Eye Disease in Recurrent Pterygium. Ophthalmic Res. In press, 2018.
- 3. Tan, J.C.K., Nguyen, V., Fenwick, E., Ferdi, A., Dinh, A., Watson, S. Vision-related quality of life in keratoconus: A Save Sight Keratoconus Registry study. Cornea. In press, 2018.
- 4. Lee, B. W.H., Tan, J.C.K., Radjenovic, Coroneo, M.T., Murrell, D.F. A review of scoring systems for ocular involvement in chronic cutaneous bullous diseases. Orphanet J Rare Dis, 2018. 13(1)•. 83.
- 5. Singh, N., George, A., Tan, J.C.K., Ewe, S., Francis I,C. Temporal Arteritis with Arteritic Anterior Ischaemic Optic Neuropathy is bilateral until proven otherwise. J Neuroophthalmol, 2016;
- 6. Tan, J.C.K., Tat, L.T., Coroneo, M.T. Treatment of partial limbal stem cell deficiency with topical interferon alpha-2b and retinoic acid. BrJ Ophthalmol, 2016. 100(7): 944948.
- 7. Tan, J.C.K., Kuo, M.X., Coroneo, M.T. Autoconjunctival Graft Compromise After Pterygium Surgery in a Patient Receiving Intravitreal Anti-Vascular Endothelial Growth Factor Injections. Cornea, 2016. 3502): 1653-1655.
- 8. Tan, J.C.K., Mann., S, Coroneo, M. T. Successful Treatment of Conjunctival Lymphangiectasia With Subconjunctival Injection of Bevacizumab. Cornea, 2016. 35(10): 1375-7.
- 9. Tan, J.C.K., Murrell, D.F., Hersch M.I. Genetic screening for human leukocyte antigen alleles prior to carbamazepine treatment. J Clin Neurosci, 2015. 22(12): 1992-3.
- 10. Tan, J.C.K/, Tat, L., Francis, K., Mendoza, C., Murrell, D.F., Coroneo, M. Prospective study of ocular manifestations of pemphigus and bullous pemphigoid identifies a high prevalence of dry eye syndrome. Cornea, 2015. 34(4): 443-8.
- 11. Tan, J.C.K., Murrell, D.F., Coroneo, M. Ocular Involvement in Autoimmune Blistering Skin Diseases. In: Murrell, D.F., editor. Blistering Diseases. New York: Springer-Verlag Berlin Heidelberg; 2015. 449-455.
- 12. Tan, J.C.K., Coroneo, M., Martinez, A., Tosti, A., Murrell, D.F. Special Issues in Epidermolysis Bullosa- Eyes, Hair, Nails, Teeth and Pregnancy. In: Murrell, D.F., editor.
- Blistering Diseases. New York: Springer-Verlag Berlin Heidelberg; 2015. 695-709.
- 13. Sebaratnam, D.F., Hanna, A.M., Chee, s.N., Frew, J.w., Venugopal, S.S., Daniel,B.S., Martin, L.K., Rhodes, L.M., Tan, J.C.K., Wang, c.Q., Welsh, B., Nijsten, T., Murrell, D.F. Development of a quality-of-life instrument for autoimmune bullous disease: the Autoimmune Bullous Disease Quality of Life questionnaire. JAMA Dermatol 2013;
LOOK FOR LIFE FOUNDATION – MATTHEW IP

Dr Matthew Hochuen Ip is a current senior resident medical officer (SRMO) at the Sydney Eye/Sydney Hospitals. Matthew graduated with BMed/MD (with Distinction) from the University of New South Wales in 2016 but has been associated with the Department of Ophthalmology at Prince of Wales Hospital since 3rd year University and has continued his passion for Ophthalmology under the mentor-ship of Professor Minas Coroneo for over 5 years.
Matthew’s research interests have focused upon the Ophthalmohelioses (sun and UV-light associated ocular pathologies), in particular pterygium, pinguecula, ocular surface squamous neoplasia and melanocytic tumours. His successful research has culminated in publications in international peer review journals including the renowned American Academy of Ophthalmology publication Ophthalmology. Matthew has also received the COSSOM Society’s Award for Best Presentation twice (2015 and 2018) illustrating the excellent quality of his research endeavors. Matthew is currently embarking upon a Master of Surgery by Thesis (UNSW) with Professor Minas Coroneo in Ophthalmology which he intends to complete by the end of 2019.
Publications:
Ip MH, Tat L, Coroneo MT. Primary acquired melanosis treated with combination interferon/retinoic acid Ophthalmology 2018; S0161-6420(18)30773-5. DOI: 1016/j.ophtha.2018.07.002
Ip MH, George R, Naing Z, Perlman EM, Rawlinson W, Coroneo MT. Topical cidofovir for treatment-refractory ocular surface squamous neoplasia Ophthalmology 2017; S0161-6420(17)33439-5. DOI: 10.1016/j.ophtha.2017.11.021.
Ip MH, Coroneo MT. The management of previously refractory ocular surface squamous neoplasia with topical cidofovir. JAMA Ophthalmology 2017; 135: 500-502; DOI:10.1001/jamaophthalmol.2017.0365
Ip MH, Chui JJ, Tat L, Coroneo MT. The significance of Fuchs’ flecks in patients with pterygium/pinguecula: earliest indicator of ultraviolet light damage? Cornea 2015; 34: 1560-1563; DOI: 10.1097/ICO.0000000000000621
Mendoza PR, Craven CM, Ip MH, Wilson MW, Coroneo MT, Grossniklaus HE. Conjunctival squamous cell carcinoma with corneal stromal invasion in presumed pterygia: a case series Ocular Oncology and Pathology 2018; 4:240-249. DOI: 1159/000485425
Awards:
- Winner for the Best Presentation of 2018; COSSOM Scientific Meeting 2018 – Department of Ophthalmology – Prince of Wales Hospital, University of New South Wales & Sydney Children’s Hospital; December, 2018
- Winner for the Best Presentation of 2015; COSSOM Scientific Meeting 2015 – Department of Ophthalmology – Prince of Wales Hospital, University of New South Wales & Sydney Children’s Hospital; December, 2015.
